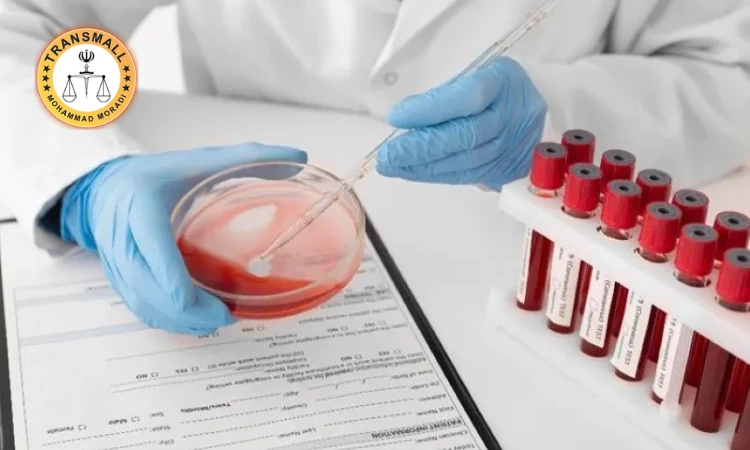
ترجمه رسمی برگ آزمایش پزشکی + نکات مهم، هزینه، زمان و تاییدات ترجمه رسمی برگ آزمایش پزشکی + نکات مهم، هزینه، زمان و تاییدات

آیا برگ آزمایش پزشکی شما برای ارائه به سفارت، دانشگاه یا مراکز درمانی خارج از کشور آماده است؟ ترجمه رسمی برگ آزمایش پزشکی به عنوان یکی از اسناد حیاتی در پرونده های مهاجرتی، تحصیلی و درمانی شناخته میشود که دقت در ترجمه واژگان تخصصی آن اهمیت دوچندان دارد. بسیاری از مراجعان در کنار مدارک هویتی مانند ترجمه رسمی شناسنامه یا مدارک پایه ای نظیر ترجمه رسمی گواهی تولد، نیازمند ارائه نتایج آزمایشات مختلف برای اثبات سلامت جسمانی یا پیگیری روند درمان در خارج از مرزها هستند. ما در دارالترجمه رسمی ترنسمال با درک حساسیت بالای مدارک پزشکی، این اسناد را توسط مترجمان مجرب قوه قضاییه که با واژگان لاتین آزمایشگاهی آشنایی کامل دارند، ترجمه میکنیم. در این مقاله جامع، تمامی ابعاد هزینه ترجمه برگ آزمایش پزشکی، پیش نیازهای قانونی برای اخذ تاییدات و مراحل انجام کار را بررسی میکنیم تا با خیالی آسوده، پرونده سلامت خود را برای مراجع بین المللی آماده کنید.
فهرست مطالب
۱. برگ آزمایش پزشکی چیست و چه انواعی دارد؟
۲. چه زمانی به ترجمه رسمی برگ آزمایش پزشکی نیاز داریم؟
۳. تفاوت ترجمه نتایج آزمایشگاهی با گواهی سلامت
۴. پیش نیازهای لازم برای تاییدات دادگستری و وزارت خارجه
۵. مراحل ترجمه رسمی مدارک پزشکی در ترنسمال
۶. هزینه ترجمه برگ آزمایش پزشکی طبق نرخنامه قانونی
۷. زمان تحویل و اعتبار قانونی ترجمه اسناد درمانی
۸. نکات هشدار و اشتباهات رایج در ترجمه آزمایشات
برگ آزمایش پزشکی چیست؟
برگ آزمایش پزشکی سندی است که حاوی نتایج بررسی های بیوشیمیایی، پاتولوژی، ژنتیک یا تصویربرداری از وضعیت بدن متقاضی میباشد و توسط آزمایشگاه های معتبر صادر میگردد. این مدرک برخلاف اسنادی مانند ترجمه رسمی مدارک تحصیلی که اطلاعاتی ثابت دارند، حاوی داده های عددی و اصطلاحات مخفف لاتین است که هرگونه اشتباه در برگردان آن ها میتواند پیامدهای جبران ناپذیری برای بیمار یا متقاضی ویزا داشته باشد. در فرآیند ترجمه رسمی، مترجم موظف است تمام شاخص های آزمایشگاهی را مطابق با استاندارد جهانی پزشکی بازنویسی کند.
انواع آزمایشات قابل ترجمه رسمی
ترجمه رسمی برگ آزمایش پزشکی طیف وسیعی از نتایج را شامل میشود که در مجموعه ترنسمال به طور تخصصی انجام میپذیرد. آزمایش های خونی شامل CBC، آزمایش های مربوط به تشخیص بیماری های عفونی، نتایج پاتولوژی و نمونه برداری، آزمایش های غربالگری و ژنتیک، و همچنین نتایج آزمایش های اعتیاد و سلامت جسمانی از پرتقاضاترین موارد هستند. همچنین در برخی موارد، این آزمایشات به عنوان ضمیمه در کنار ترجمه رسمی گواهی فوت برای بررسی علل فوت در پرونده های حقوقی خارج از کشور مورد استفاده قرار میگیرند.
چه زمانی به ترجمه رسمی برگ آزمایش پزشکی نیاز داریم؟
برگ آزمایش پزشکی در سناریوهای مختلف مهاجرتی و درمانی به عنوان یک مدرک پشتیبان عمل میکند. برای مثال، بسیاری از کشورها برای صدور ویزای بلندمدت یا اقامت دائم، متقاضی را ملزم به ارائه نتایج آزمایشات خاصی میکنند تا از عدم ابتلای وی به بیماری های واگیردار اطمینان حاصل کنند. این موضوع در کنار ارائه ترجمه رسمی سوابق کاری برای مهاجرت های شغلی، پکیج کاملی از صلاحیت های فرد را به کشور مقصد ارائه میدهد.
در اینجا به سه مورد از اصلی ترین کاربردهای این ترجمه اشاره میکنیم:
- ویزای مهاجرتی و اقامتی: بسیاری از کنسولگری ها آزمایش های سلامت (Medical Exam) را برای تایید پرونده نهایی درخواست میکنند.
- پذیرش تحصیلی در رشته های خاص: برخی دانشگاه ها برای ثبت نام دانشجویان در رشته های علوم پزشکی، ارائه آزمایش های ایمنی و واکسیناسیون را الزامی میدانند که باید در کنار ترجمه رسمی ریزنمرات ارائه شود.
- پیگیری درمان در خارج از کشور: ارسال سوابق آزمایشگاهی برای پزشکان متخصص در کشورهای دیگر جهت تشخیص بهتر و ادامه روند درمان.
تفاوت ترجمه نتایج آزمایشگاهی با گواهی سلامت
برگ آزمایش پزشکی صرفا داده های خام آزمایشگاهی را نشان میدهد، در حالی که گواهی سلامت یک نامه تاییدیه از سوی پزشک است که بر اساس آن آزمایشات صادر شده است. در نظام دارالترجمه رسمی، هر دو مدرک قابلیت ترجمه دارند اما پیش نیازهای تایید آن ها متفاوت است. برای مثال، اگر شما آزمایشگاهی خصوصی داشته باشید، نتایج آن تنها با مهر پزشک مسئول فنی آزمایشگاه قابل ترجمه است، اما برای اخذ تاییدات دولتی، شرایط پیچیده تری حاکم است.
هماهنگی مدارک پزشکی با اسناد هویتی
ترجمه رسمی برگ آزمایش پزشکی باید از نظر اطلاعات فردی کاملا با ترجمه رسمی شناسنامه و پاسپورت متقاضی مطابقت داشته باشد. هرگونه اختلاف در اسپل نام و نام خانوادگی یا تاریخ تولد در برگه آزمایش نسبت به پاسپورت، میتواند منجر به بی اعتباری مدرک در نزد سفارت شود. ما در دارالترجمه رسمی ترنسمال با دقت بالایی این تطبیق را انجام میدهیم تا هیچ مغایرتی در پرونده شما ایجاد نشود. همچنین اگر آزمایش متعلق به نوزاد یا کودک باشد، تطبیق آن با ترجمه رسمی گواهی تولد الزامی است.
پیش نیازهای ترجمه رسمی برگ آزمایش پزشکی
ترجمه رسمی مدارک پزشکی حساسیت های قانونی ویژه ای دارد زیرا با سلامت جامعه در ارتباط است. برخلاف اسنادی نظیر ترجمه رسمی سند ازدواج که یک بار صادر میشوند، برگه های آزمایش دارای تاریخ صدور هستند و اعتبار آن ها توسط مراجع پذیرنده محدود در نظر گرفته میشود.
برای اینکه سفارش شما در ترنسمال بدون مشکل پیش برود، رعایت این لیست ضروری است:
۱. مهر پزشک مسئول فنی: تمام برگه های آزمایشگاه باید دارای مهر زنده و امضای پزشک متخصص مسئول فنی آزمایشگاه باشند.
۲. تاییدیه سازمان نظام پزشکی: برای اخذ تاییدات دادگستری و وزارت امور خارجه، مهر و امضای پزشک باید توسط سازمان نظام پزشکی تایید شده باشد.
۳. سربرگ رسمی آزمایشگاه: نتایج آزمایش باید حتما روی کاغذ رسمی و ممهور آزمایشگاه صادر شده باشند و کپی یا پرینت ساده بدون مهر قابل ترجمه رسمی نیست.
مراحل ترجمه رسمی برگ آزمایش پزشکی در ترنسمال
برگ آزمایش پزشکی به دلیل وجود مقادیر عددی و اختصارات تخصصی، فرآیند ترجمه متفاوتی نسبت به متون عمومی دارد. ما در دارالترجمه رسمی ترنسمال برای جلوگیری از کوچکترین خطای انسانی، یک سیستم بازبینی دو مرحله ای را طراحی کرده ایم تا پلمب نهایی بدون هیچ گونه ایرادی صادر شود. این دقت به ویژه زمانی که نتایج آزمایش برای تشخیص بیماری های جدی به پزشکان خارجی ارائه می شود، اهمیت حیاتی پیدا می کند.
مراحل اجرایی این خدمت در مجموعه ما به شرح زیر است:
- کارشناسی و تایید اعتبار مدرک: ابتدا اصل برگه آزمایش توسط کارشناس دارالترجمه بررسی می شود تا مهرهای مسئول فنی آزمایشگاه و در صورت نیاز، تاییدیه نظام پزشکی محرز گردد.
- تطبیق اطلاعات هویتی با پاسپورت: نام و نام خانوادگی متقاضی با ترجمه رسمی شناسنامه و گذرنامه تطبیق داده می شود تا در نتایج آزمایشگاهی هیچ مغایرتی وجود نداشته باشد.
- برگردان تخصصی واژگان آزمایشگاهی: مترجم رسمی با استفاده از دیکشنری های تخصصی پزشکی (Medical Dictionaries)، تمامی اختصارات و پارامترهای بیوشیمیایی را به معادل های استاندارد بین المللی تبدیل می کند.
- اخذ تاییدات دادگستری و خارجه: پس از اتمام ترجمه بر روی سربرگ قوه قضاییه، پلمب مدارک جهت اخذ مهرهای نهایی به وزارتخانه های مربوطه ارسال می گردد.
- تحویل نهایی به متقاضی: نسخه تایید شده به همراه اصل مدارک از طریق پیک ایمن یا به صورت حضوری تحویل داده می شود.

هزینه ترجمه رسمی برگ آزمایش پزشکی و تعرفه دولتی
هزینه ترجمه رسمی مدارک پزشکی بر اساس نرخنامه مصوب سالانه قوه قضاییه محاسبه می گردد. از آنجایی که برگه های آزمایش معمولا شامل جداول و لیست های عددی هستند، قیمت گذاری بر اساس تعداد سطور آزمایش یا تعداد کلمات متن اصلی انجام می شود. شفافیت در محاسبه هزینه ها یکی از اصول ما در دارالترجمه رسمی ترنسمال است و شما می توانید پیش از ثبت سفارش، استعلام دقیق قیمت را دریافت کنید.
عوامل تاثیرگذار بر قیمت نهایی شامل موارد زیر است:
- حجم پارامترهای آزمایشگاهی: هرچه تعداد فاکتورهای مورد آزمایش (مانند قند خون، کلسترول، شمارش گلبول ها و غیره) بیشتر باشد، حجم کار مترجم و در نتیجه هزینه افزایش می یابد.
- نیاز به تاییدات اضافه: هزینه بارکد دادگستری و مهر وزارت امور خارجه که به صورت جداگانه طبق تعرفه دولتی دریافت می شود.
- هزینه خدمات دفتری: شامل هزینه های مربوط به پلمب رسمی و کپی برابر اصل مدارک که برای تمامی نسخه ها اعمال می گردد.
- فوریت در انجام سفارش: اگر نیاز به ترجمه فوری داشته باشید، اولویت دهی به پرونده شما شامل هزینه های فوریت طبق نرخنامه خواهد بود.
زمان مورد نیاز برای تحویل ترجمه مدارک پزشکی
زمان ترجمه برگ آزمایش پزشکی در حالت عادی بین ۲ تا ۳ روز کاری است. این بازه زمانی به مترجم فرصت می دهد تا با دقت تمامی ردیف های عددی را بازبینی کند. با این حال، ما به خوبی می دانیم که در موارد اورژانسی درمانی یا ددلاین های سفارت، حتی یک ساعت هم برای شما حیاتی است. به همین منظور، بخش ترجمه فوری در ترنسمال راه اندازی شده است تا اسناد شما را در کمتر از ۲۴ ساعت آماده کند.
در نظر داشته باشید که اگر مدرک شما نیاز به تایید سازمان نظام پزشکی و سپس دادگستری داشته باشد، باید زمانی حدود ۲ تا ۴ روز کاری اضافه را برای این پروسه اداری پیش بینی کنید. برای صرفه جویی در زمان، توصیه می شود همزمان با آماده سازی سایر مدارک مانند ترجمه رسمی مدارک تحصیلی یا شغلی، آزمایشات خود را نیز به دارالترجمه برسانید تا تاییدات تمامی مدارک به صورت همزمان انجام شود.
اهمیت دقت در ترجمه اختصارات و رنج های عددی
ترجمه رسمی مدارک درمانی نیازمند دانش فنی در مورد واحدهای اندازه گیری پزشکی است. برای مثال، تبدیل واحدهای میلی گرم در دسی لیتر به میلی مول در لیتر در برخی آزمایشات تخصصی باید با دقت انجام شود تا پزشک مقصد دچار اشتباه در تشخیص نشود. مترجمان ما در دارالترجمه رسمی ترنسمال به خوبی می دانند که یک جابجایی ساده در ممیزهای اعداد می تواند منجر به تفسیر کاملا متفاوتی از وضعیت سلامت فرد شود.
علاوه بر این، اختصارات آزمایشگاهی (Abbreviations) در کشورهای مختلف ممکن است متفاوت باشند. وظیفه مترجم رسمی این است که این اختصارات را به شکلی ترجمه کند که در سیستم درمانی کشور مقصد کاملا استاندارد و قابل فهم باشد. این موضوع در کنار ارائه ترجمه رسمی سوابق کاری (برای مشاغل مرتبط با بهداشت و درمان) یا ترجمه رسمی گواهی تولد، به تقویت پرونده مهاجرتی یا درمانی شما کمک شایانی می کند.
تاییدات وزارت بهداشت و سازمان نظام پزشکی
تایید دادگستری برای برگ آزمایش پزشکی منوط به وجود مهرهای اولیه مراجع ذی صلاح است. طبق قوانین ایران، آزمایشاتی که در بخش خصوصی انجام می شوند باید حتما به تایید سازمان نظام پزشکی برسند. بدون این مهر، حتی با وجود مهر مسئول فنی آزمایشگاه، دادگستری و وزارت امور خارجه از تایید ترجمه خودداری خواهند کرد. این سخت گیری به دلیل اهمیت بالای مدارک پزشکی در روابط بین الملل است.
اگر آزمایش شما در بیمارستان های دولتی یا زیر نظر دانشگاه های علوم پزشکی انجام شده باشد، ممکن است نیاز به مهر معاونت درمان دانشگاه مربوطه داشته باشید. ما در دارالترجمه رسمی ترنسمال راهنمایی های لازم را برای دریافت این مهرها به شما ارائه می دهیم تا از ترددهای بی مورد در ادارات جلوگیری شود. هماهنگی این تاییدات با مدارک هویتی مثل ترجمه رسمی شناسنامه تضمین می کند که هویت صاحب آزمایش برای مراجع خارجی کاملا احراز شده است.
اعتبار قانونی و تاریخ انقضای ترجمه مدارک پزشکی
برگ آزمایش پزشکی برخلاف مدارکی مانند ترجمه رسمی سند ازدواج یا دانشنامه که اعتبار دائمی دارند، سندی با تاریخ انقضای بسیار محدود است. از دیدگاه سفارتخانهها و مراکز درمانی بینالمللی، نتایج یک آزمایش خون یا غربالگری تنها برای مدت زمان کوتاهی (معمولا بین ۱ تا ۳ ماه) وضعیت فعلی سلامت شما را منعکس میکند. بنابراین، انجام ترجمه رسمی این مدارک باید در نزدیکترین زمان ممکن به ددلاین ارائه مدارک صورت گیرد.
در دارالترجمه رسمی ترنسمال، ما همواره به مراجعان توصیه میکنیم که ابتدا از بازه زمانی مورد قبول سفارت مقصد مطلع شوند. برای مثال، آزمایشهای مربوط به بیماریهای واگیردار برای ویزای کشورهایی مثل انگلستان یا استرالیا، نباید بیش از ۶ ماه از تاریخ صدورشان گذشته باشد. اگر اعتبار آزمایش شما در حال اتمام است، بهتر است ابتدا آزمایش را تمدید و سپس برای ترجمه اقدام کنید تا هزینههای ترجمه رسمی شما هدر نرود.
نکات امنیتی و محرمانگی در ترجمه اسناد درمانی
ترجمه رسمی مدارک پزشکی شامل حساسترین اطلاعات خصوصی یک فرد است. ما در دارالترجمه رسمی ترنسمال به خوبی میدانیم که نتایج آزمایشات پاتولوژی، ژنتیک یا اعتیاد باید در بستری کاملاً امن و محرمانه نگهداری شوند. طبق اصول اخلاق حرفهای مترجمان قوه قضاییه، تمامی اطلاعات مندرج در برگ آزمایش پزشکی شما نزد ما امانت بوده و هیچ شخص ثالثی به آنها دسترسی نخواهد داشت.
رعایت استانداردهای امنیتی در مجموعه ما شامل موارد زیر است:
- بایگانی امن: تمامی اسکنها و فایلهای متنی پس از تحویل پلمب نهایی و تایید مشتری، طبق پروتکلهای حفاظتی از سیستمهای موقت حذف میگردند.
- عدم انتشار نمونهها: برخلاف سایر مدارک، ما هرگز از نمونههای واقعی آزمایشات مشتریان برای آموزش یا بازاریابی استفاده نمیکنیم.
- تحویل محرمانه: پلمب مدارک در بستهبندیهای کاملا پوشیده و تنها به شخص متقاضی یا وکیل قانونی وی که با ارائه ترجمه رسمی شناسنامه احراز هویت شده باشد، تحویل داده میشود.
برگ آزمایش پزشکی معمولاً به تنهایی ارائه نمیشود و بخشی از یک پکیج کامل سلامت است. برای مثال، اگر متقاضی دریافت ویزای درمانی هستید، باید علاوه بر آزمایشات، ترجمه رسمی گواهی پزشک و مدارک هویتی خود را نیز آماده کنید. هماهنگی بین این مدارک نشاندهنده نظم و اعتبار پرونده شماست.

سوالات متداول درباره ترجمه برگ آزمایش
ترجمه رسمی اسناد پزشکی سوالات زیادی را برای مراجعان ایجاد میکند که پاسخ به آنها میتواند مسیر اداری شما را کوتاه کند.
در ادامه به سه مورد از پرتکرارترین سوالات پاسخ دادهایم:
- آیا نتایج آزمایشی که به زبان انگلیسی صادر شده نیاز به ترجمه رسمی دارد؟ بله، حتی اگر آزمایشگاه نتایج را به انگلیسی چاپ کرده باشد، برای اخذ تاییدات دادگستری و وزارت امور خارجه ایران، باید توسط مترجم رسمی روی سربرگ قوه قضاییه تایید و پلمب شود تا وجاهت قانونی پیدا کند.
- آیا آزمایشهای چکاپ معمولی هم قابل ترجمه رسمی هستند؟ بله، هر نوع برگ آزمایش پزشکی که دارای مهر مسئول فنی آزمایشگاه باشد، قابلیت ترجمه رسمی را دارد، اما تاییدات دولتی آن منوط به تایید سازمان نظام پزشکی است.
- اگر نام بیمار در برگه آزمایش اشتباه تایپ شده باشد چه باید کرد؟ در این صورت مترجم رسمی اجازه تغییر نام را ندارد. شما باید ابتدا به آزمایشگاه صادرکننده مراجعه کرده و درخواست اصلاح و صدور مجدد برگه را بدهید، زیرا اطلاعات باید دقیقاً با ترجمه رسمی شناسنامه مطابقت داشته باشد.
ترجمه رسمی برگ آزمایش پزشکی توسط تیم حرفه ای ترنسمال
ترجمه رسمی برگ آزمایش پزشکی سندی است که مستقیماً با سرنوشت پروندههای مهاجرتی و درمانی شما گره خورده است. کوچکترین خطا در برگردان اعداد یا اصطلاحات لاتین میتواند منجر به تفسیر نادرست پزشکان یا ماموران کنسولی شود. ما در دارالترجمه رسمی ترنسمال با بهرهگیری از تیم تخصصی و ویراستاران آشنا به دانش پزشکی، تضمین میکنیم که مدارک شما با بالاترین ضریب دقت ترجمه شوند.
فرقی نمیکند که به دنبال ترجمه رسمی مدارک تحصیلی هستید یا نیاز به ترجمه فوری آزمایشات خود برای یک سفر اضطراری درمانی دارید؛ تیم ما در تمامی مراحل از اخذ تاییدیه نظام پزشکی تا دریافت مهرهای وزارت امور خارجه در کنار شماست. همین حالا با کارشناسان ما تماس بگیرید تا از مشاوره رایگان و برآورد دقیق هزینهها بهرهمند شوید و با اطمینان کامل، مدارک سلامت خود را به مراجع بینالمللی ارائه دهید.








